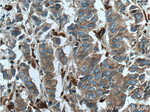
EML4 Antibody in Immunohistochemistry (Paraffin) (IHC (P))
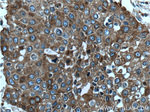
EML4 Antibody in Immunohistochemistry (Paraffin) (IHC (P))

Search
Proteintech
EML4 Polyclonal Antibody
{{$productOrderCtrl.translations['antibody.pdp.commerceCard.promotion.promotions']}}
{{$productOrderCtrl.translations['antibody.pdp.commerceCard.promotion.viewpromo']}}
{{$productOrderCtrl.translations['antibody.pdp.commerceCard.promotion.promocode']}}: {{promo.promoCode}} {{promo.promoTitle}} {{promo.promoDescription}}. {{$productOrderCtrl.translations['antibody.pdp.commerceCard.promotion.learnmore']}}
产品信息
22709-1-AP
种属反应
宿主/亚型
分类
类型
抗原
偶联物
形式
浓度
规格
纯化类型
保存液
内含物
保存条件
运输条件
产品详细信息
Immunogen sequence: GSLDDSISA ASTSDVQDRL SALESRVQQQ EDEITVLKAA LADVLRRLAI SEDHVASVKK SVSSKGQPSP RAVIPMSCIT NGSGANRKPS HTSAVSIAGK ETLSSAAKSG TEKKKEKPQG QREKKEESHS NDQSPQIRAS PSPQPSSQPL QIHRQTPESK NATPTKSIKR PSPAEKSHNS WENSDDSRNK LSKIPSTPKL IPKVTKTADK HKDVIINQEG EYIKMFMRGR PITMFIPSDV DNYDDIRTEL PPEKLKLEWA YGYRGKDCRA NVYLLPTGEI VYFIASVVVL FNYEERTQRH YLGHTDCVKC LAIHPDKIRI ATGQIAGVDK DGRPLQPHVR VWDSVTLSTL QIIGLGTFER GVGCLDFSKA DSGVHLCVID DSNEHMLTVW DWQKKAKGAE IKTTNEVVLA VEFHPTDANT IITCGKSHIF FWTWSGNSLT RKQGIFGKYE KPKFVQCLAF LGNGDVLTGD SGGVMLIWSK TTVEPTPGKG PKGVYQISKQ IKAHDGSVFT LCQMRNGMLL TGGGKDRKII LWDHDLNPER EIEVPDQYGT IRAVAEGKAD QFLVGTSRNF ILRGTFNDGF QIEVQGHTDE LWGLATHPFK DLLLTCAQDR QVCLWNSMEH RLEWTRLVDE PGHCADFHPS GTVVAIGTHS GRWFVLDAE (6-663 aa encoded by BC140845 )
靶标信息
Transcription of protein-coding genes can be reconstituted on naked DNA with only the general transcription factors and RNA polymerase II. However, this minimal system cannot transcribe DNA packaged into chromatin, indicating that accessory factors may facilitate access to DNA. One such factor, FACT, interacts specifically with histones H2A/H2B to effect nucleosome disassembly and transcription elongation. FACT is composed of an 80 kDa subunit and a 140 kDa subunit; this gene encodes the 140 kDa subunit.
仅用于科研。不用于诊断过程。未经明确授权不得转售。
篇参考文献 (0)
生物信息学
蛋白别名: echinoderm microtubule associated protein like 4; Echinoderm microtubule-associated protein-like 4; EMAP-4; EML4/ALK fusion protein; OTTHUMP00000201447; OTTHUMP00000201455; Restrictedly overexpressed proliferation-associated protein; Ropp 120; unnamed protein product
基因别名: C2orf2; ELP120; EMAP-4; EMAPL4; EML4; ROPP120
UniProt ID: (Human) Q9HC35
Entrez Gene ID: (Human) 27436